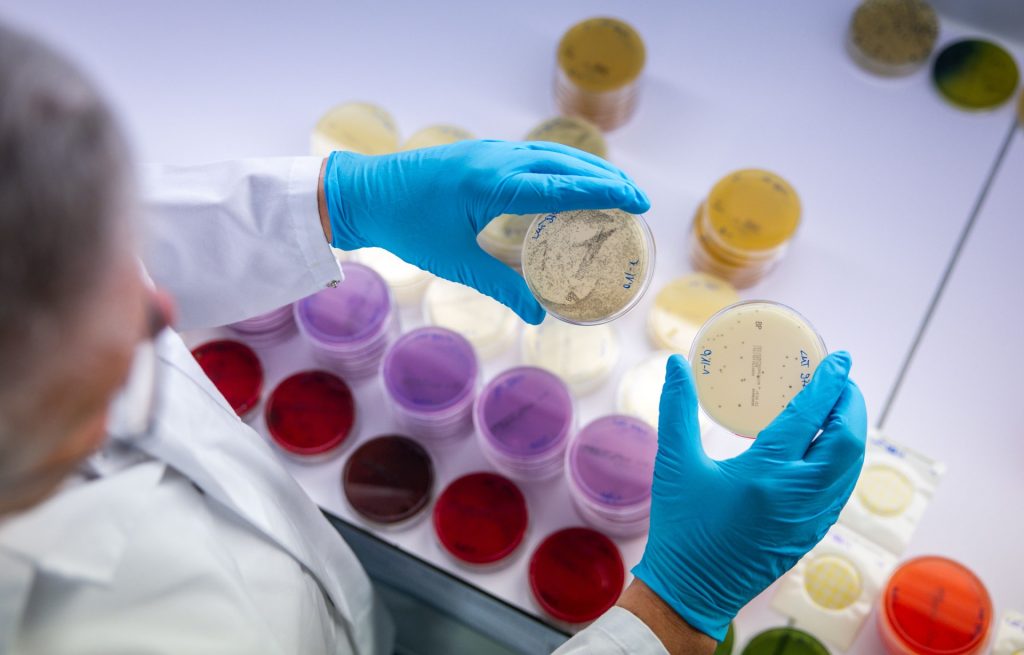
Bund vergibt künftig weniger aber höhere Exzellenz-Stipendien

Bundesrat will keine zusätzliche Ferienwoche in der Lehrzeit
Baseljetzt
Der gesetzliche Ferienanspruch während der Berufslehre soll nicht auf mindestens sechs Wochen erhöht werden. Der Bundesrat lehnt fünf entsprechende Motionen aus mehreren Fraktionen ab.
Ständerätin Flavia Wasserfallen (SP/BE) sowie die Nationalrätinnen Franziska Ryser (Grüne/SG) und Fabienne Stämpfli (GLP/BE) und die Nationalräte Marc Jost (EVP/BE) und Simon Stadler (Mitte/UR) fordern mit fünf gleichlautenden Motionen, das Obligationenrecht entsprechend anzupassen.
Dabei soll der Bundesrat untersuchen, wie Lehrbetriebe im Gegenzug entlastet werden könnten. Die Motionärinnen und Motionäre begründen ihr Anliegen damit, dass Jugendliche auch wegen der längeren Schulferien zunehmend das Gymnasium wählten statt eine Berufslehre. Ausserdem nähmen psychische Belastungen in der Lehre zu.
Der Bundesrat stellt sich gemäss seiner am Donnerstag veröffentlichten Stellungnahme gegen die Motionen. Schon heute hätten Betriebe die Möglichkeit, ihren Lernenden mehr Ferien zu gewähren als die gesetzlich vorgeschriebenen fünf Wochen. Das sei für sie eine Chance, im Wettbewerb um Lernende zu punkten.
Fehlten Lernende eine Woche mehr bei der Arbeit, könne das die Ausbildungsbereitschaft der Betriebe senken, warnt der Bundesrat zudem. Unter 30-Jährige können zudem für freiwillige Engagements in der ausserschulischen Jugendarbeit fünf Tage unbezahlten Urlaub beantragen. Die vom Parlament verlangte Erhöhung auf bis zu zwei Wochen kam in der Vernehmlassung laut dem Bundesrat gut an.
Der Bundesrat will schliesslich Ergebnissen eines Runden Tisches zur Berufsbildung nicht vorgreifen. An der Zusammenkunft würden die Rahmenbedingungen für die Berufslehre untersucht, darunter der Ferienanspruch. Dabei spricht der Bundesrat auch ein degressives Modell über die gesamte Lehrzeit an.
Eine vor Kurzem eingereichte Petition an den Bundesrat verlangte gar acht Wochen Ferien für Jugendliche in der Berufslehre. Das Anliegen stiess auf viel Zustimmung, rund 176’450 Personen unterzeichneten die Petition. Es sei eine Rekord-Petition, schrieb die dafür aus Lernenden gegründete Allianz zu der Bittschrift. (sda/jab)
Mehr dazu
Feedback für die Redaktion
Hat dir dieser Artikel gefallen?
Kommentare
Dein Kommentar
Mit dem Absenden dieses Formulars erkläre ich mich mit der zweckgebundenen Speicherung der angegebenen Daten einverstanden. Datenschutzerklärung und Widerrufshinweise
Kommentare lesen?
Um Kommentare lesen zu können, melde dich bitte an.

Hoschi
Dies ist auch sinnvoll so meiner Meinung nach.